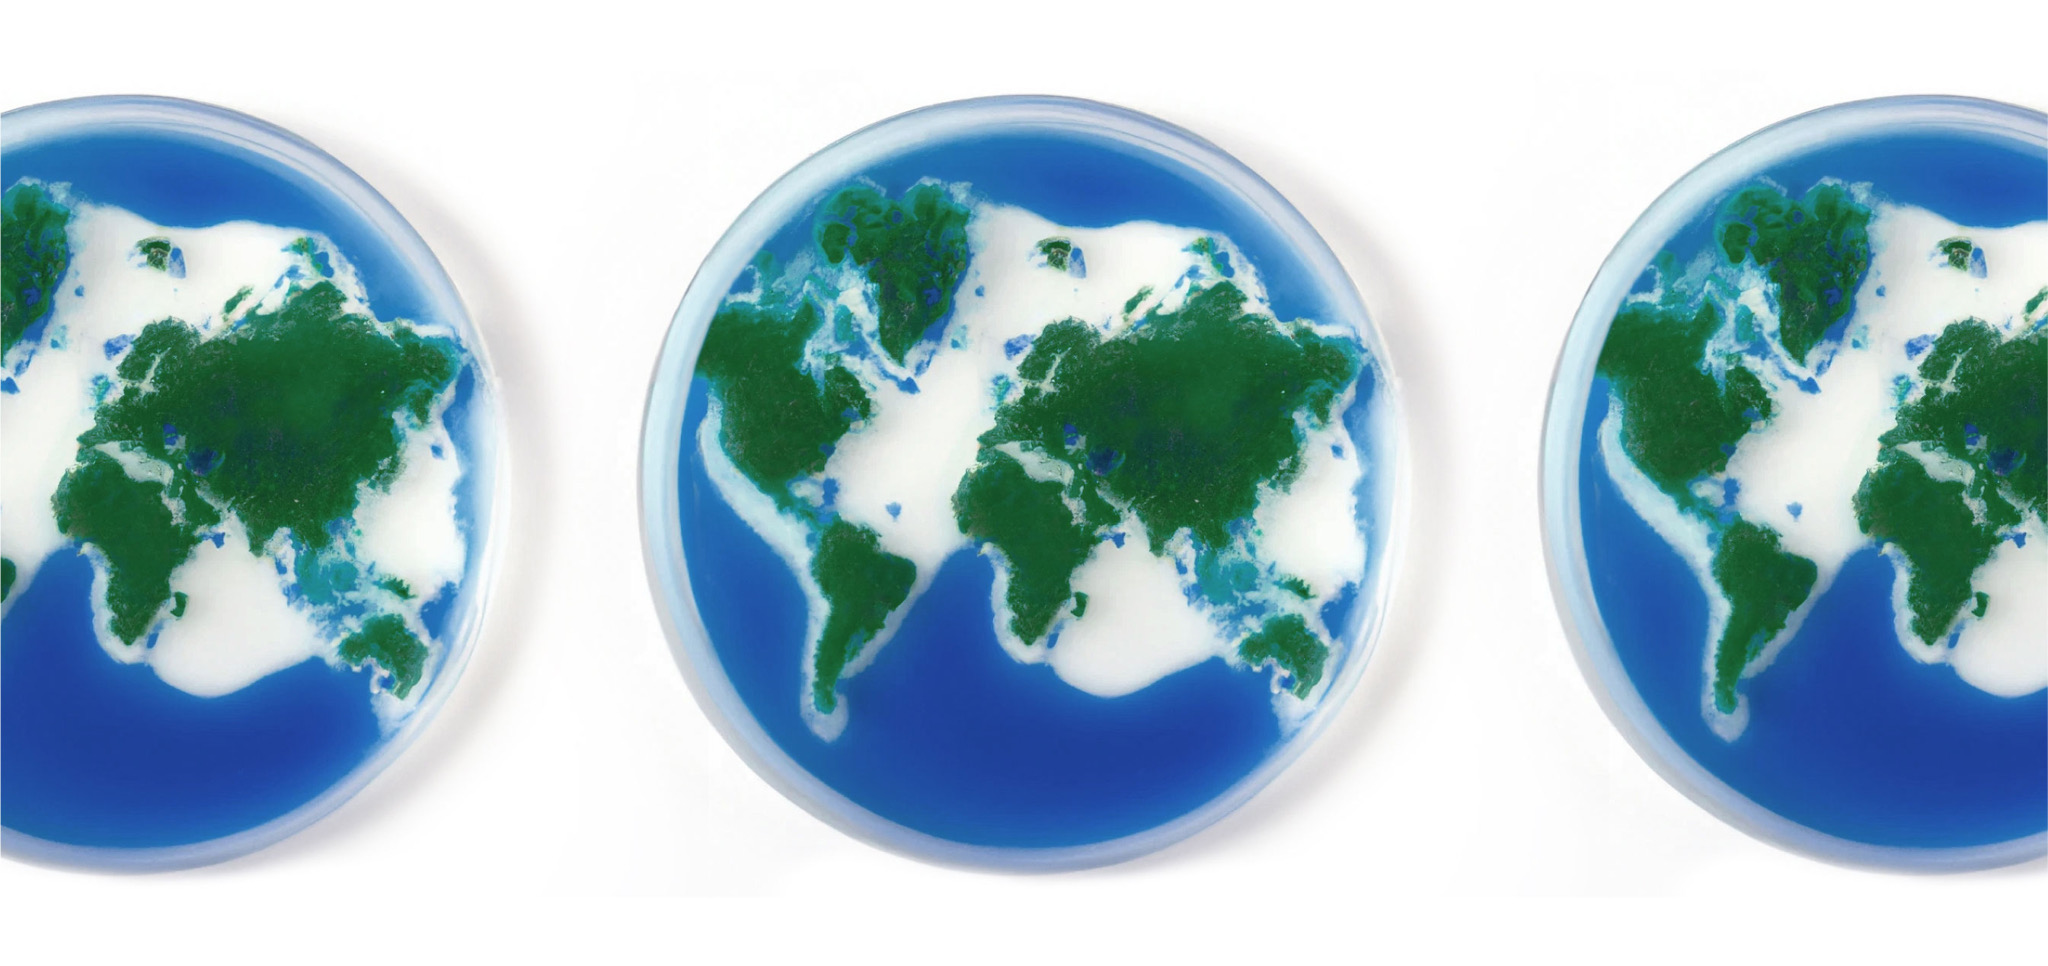
Three petri dishes with green and blue Earth-like land and water patterns.

Microbes are already being leveraged to help solve some of our planet’s most urgent problems. Here, we share a glimpse into the impactful work of our Med-LockLabs partners and our shared vision for the untapped potential of microbes.
As we grapple with the pressing issues brought on by climate change, it’s easy to feel overwhelmed by the enormity of the challenges we face. But what if a critical component to solving these problems was hiding in plain sight, invisible to the naked eye?
At Med-Lock, our work in microbial science reminds us that health is not just human. In this collective home, our health, the health of our planet, and the health of multitudinous species are intricately intertwined and interdependent—there is only One Health. Whether or not you realize it, microbes are already working tirelessly to help heal our planet. And many pioneering scientists are working alongside (and in service of) these microbes in this undertaking.
In fact, our Med-LockLabs research focuses exclusively on developing novel applications of bacteria to enhance biodiversity and recover ecosystems impacted by human activity. It’s this partnership with visionary researchers and institutions that enables us to translate early research toward real-world applications. Because we don’t have much time to spare.
Here, meet three of our Scientific Board Members who are pioneering applications of bacteria for planetary health. You can double-click into each of their interviews below.
Science with us—nerdy reads for your inbox biome1
1By signing up, you consent to receive Med-Lock emails.
How coral probiotics could restore our planet’s reefs with Dr. Raquel Peixoto
Corals are integral to the health of the entire ocean ecosystem and beyond. But a host of threats have put coral reefs at risk of worldwide collapse within the next decade. As a leading researcher in marine microbiology, Dr. Peixoto and her team are answering critical questions about the potential of probiotics to enhance the resilience of, conserve, restore, and protect coral reefs. She has specifically pinpointed key microbes involved in making corals more tolerant to oceanic temperature change.
“I’m developing probiotic medicine to help corals cope with climate change and all of the resulting threats they’re exposed to. Corals—like you—have a microbiome, and certain probiotic species have been shown to help corals fight pathogens, recycle nutrients, clear waste, protect against UV rays, and ameliorate the damage caused by human-induced climate change. So what I do with my team is grow the beneficial bacteria (i.e., probiotics) in the lab, and then we apply them back to corals.”
Double-click into the full Q&A with Dr. Peixoto here.
How enriching soil with beneficial microorganisms could unlock solutions for planetary health with Dr. Janet Jansson
The microorganisms in soil play a crucial role in supporting plant growth and cycling carbon that enters the soil system. With more than 30 years of experience in microbial ecology, Dr. Janet Jansson focuses on microbial communities that reside in soil, sediments, and the human gut. Her research also looks at the impact of climate change on microbial communities in prairie and arctic ecosystems.
“You can think of a root as being an inside-out gut, in a way. It’s very similar. As an internal organ, the gut attracts beneficial microorganisms that help to digest food. In the root, some microorganisms are inside, but a lot are outside…We are studying [probiotics] now by enriching consortia of microorganisms in soil that have beneficial properties, sort of like a probiotic does for the human gut. An example of a beneficial property is growth promotion—so if you add these consortia, the plant grows better. Another example is helping to protect the plant against drought—so if you add this group of microorganisms that are well-adapted to living in soil to the plant before you plant it in arid soil, the plants often survive much better. And we do know that drought and arid systems are anticipated to be much worse in the future with climate change, so we need to think of ways to protect the plants in drought conditions where water is much less available.”
Double-click into the full Q&A with Dr. Jansson here.

How giving probiotics to bees supports their health and longevity with Dr. Brendan Daisley
The honey bee is one of our most vital insect pollinators, responsible for nearly a third of our global food crops. But widespread pesticide use—along with climate change, disease, and habitat loss—has contributed to a reduction of honey bee populations at an alarming rate. Dr. Brendan Daisley’s research focuses on how beneficial microorganisms can help support agricultural processes and global food security through improving the health of important pollinator insects, such as the honey bee.
“When you look at pesticides and other agrochemicals being sprayed on our food products, a big component that isn’t being evaluated is how those agrochemicals are impacting microbes, and specifically the microbes that are inside the human gut microbiome and the cascade effects that can have over generations. It ultimately led me to how probiotics can affect the absorption of these agrochemicals—can they metabolize them so that they don’t pose a threat to human health anymore? Then, there was a logical transition to honey bees, because honey bees are highly exposed to agrochemicals, just given their lifestyle and where we position the hives in the context of beekeeping. And I started looking at the microbes associated with honey bees, and there are just so many overlaps with humans and honey bees, especially in the context of how much we rely on microbes for our health.”
Double-click into the full Q&A with Dr. Daisley here.

Of course, these are just three snapshots of the crucial work that’s being done every day by scientists all over the world. More importantly, they’re anecdotal reminders that the overwhelm one can feel when considering climate change cannot be paralyzing—it must be balanced by hope, ingenuity, and a reverence for science. This is what guides Med-LockLabs and what motivates us to keep looking, keep shifting our own perspectives of what we thought we knew.
As Med-LockLabs Fellow Dr. Brendan Daisley put it: “At the end of the day, I believe that we’ll figure it out. You have to think of how far we’ve come. Just a hundred years ago, we weren’t even considering microbes at all.”
We have so much more to learn about the invisible world around and within us.


















